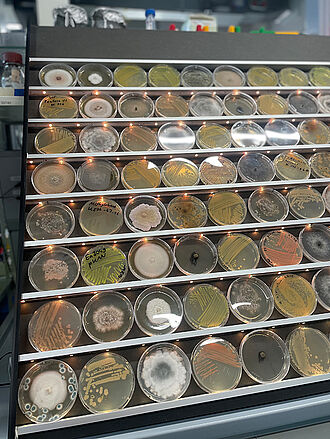
Wildes Sammelsurium im "Mikrobenzoo". © Sarah Barnert/JKI

Am Sonntag, den 13. Juli 2025, öffnete das JKI in Dossenheim seine Türen für die interessierte Öffentlichkeit – und die Wissbegierde war groß: Rund 950 Gäste nutzten die Gelegenheit, einen Blick hinter die Kulissen der Forschung zu werfen. Der Tag der offenen Tür stand dieses Jahr unter dem Motto „Angriff und Verteidigung in Obstbaum, Beet und Feld“ und bot ein vielfältiges Programm mit spannenden Stationen im Labor, Gewächshaus und Freiland.
Die beiden Fachinstitute am Standort – das Institut für Pflanzenschutz in Obst- und Weinbau unter der Leitung von Prof. Dr. Jürgen Gross sowie das Institut für Biologischen Pflanzenschutz unter der Leitung von Prof. Dr. Johannes A. Jehle – präsentierten ihre Arbeit anschaulich und praxisnah. Thematisch reichte die Bandbreite von Apfelwickler und Kirschessigfliege über Feuerbrand und Apfeltriebsucht bis hin zu ihren natürlichen Gegenspielern wie etwa der Samurai-Wespe.